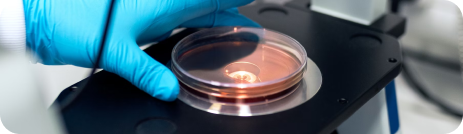
Получение детальной информации о процессе биоокисления флотоконцентратов и очистке оборотной воды бактериальным методом

Центр промышленных биотехнологий
Исследования и разработки
развитие ведущей научной школы в биотехнологиях для горно-металлургической отрасли
Подготовка кадров
передовые образовательные программы в области подготовки инженеров, исследователей и руководителей биотехнологических производств
Консалтинг
разработка и сопровождение проектов организации биотехнологических производств для ГМК

Биотехнологии в области горно-добывающей промышленности
- 01
Ключевое преимущество
Преимуществом применения биотехнологий для добычи полезных металлов считается повышение уровня их извлечения, которое в таком случае достигнет в среднем более 90%, и меньшие операционные расходы за счет простоты аппаратурного оформления
- 02
Устойчивое развитие
Биотехнологии обеспечивают устойчивое развитие отрасли оказывая минимальное негативное воздействие на окружающую среду и здоровье человека
- 03
Отечественные технологии
Потребность в развитии отечественных технологий на фоне ограниченного доступа к иностранным и постепенное истощение богатых руд требуют разработки принципиально новых по стоимости и эффективности технологических решений в горной биохимии с их последующим трансфером в промышленность

Продукты и услуги
Горно-металлургическая промышленность

- Биовыщелачивание цветных и благородных металлов из руд, концентратов и отвалов
- Селективное разделение полиметаллических руд и концентратов
- Повышение качества концентратов и руд
- Биосорбция и концентрирование металлов из сточных вод предприятий горнодобывающей промышленности
- Исследование разнообразия микроорганизмов на горно-обогатительных комбинатах с целью выявления их свойств и использования в горной биотехнологии
- Подготовка коллективных концентратов к циклу селекции посредством деградации плёнок ПАВ
Угольная и нефтегазовая промышленность

- Снижение содержания метана в угольных шахтах
- Извлечение редкоземельных элементов из угольной золы
- Десульфуризация каменного угля
- Биопереработка бурых углей
- Повышение нефтеотдачи пластов
Экологические биотехнологии

- Биоочистка промышленных стоков
- Биоочистка газовых выбросов
- Ликвидация разливов топлива и нефти
- Био- и фиторегенерация хвостохранилищ и рудных отвалов, в том числе добыча редкоземельных металлов из отвалов
Наука

Проведение комплексных исследований по разработке и совершенствованию технологических схем бактериального окисления золотосодержащих, полиметаллических руд и концентратов

Получение информации о физиологической и биохимической активности входящих в ассоциацию микроорганизмов с применением современных методов анализа

Разработка и оптимизация технологических схем очистки оборотной воды бактериальным методом

Мониторинг системы водооборота, включающий гидробиологический, гидрохимический мониторинг водных объектов, биоремедиации

Разработка и внедрение оригинальных методик по определению физиологической активности микроорганизмов, распределению микроорганизмов в жидкой и твердой фазы при биоокислении флотоконцентратов, определению доли серо- и железоокисляющих микроорганизмов в биопульпе, их концентрации

Получение детальной информации о процессе биоокисления флотоконцентратов и очистке оборотной воды бактериальным методом

Разработка исходных данных для ТЭС, ТЭО, ТЭР. Разработка качественно количественных и водошламовых схем. Подготовка оперативных рекомендаций по ведению процессов бактериального окисления

Разработка и внедрение маломасштабного лабораторного оборудования – лабораторных реакторов, установок определения физиологической активности микроорганизмов, измерение концентрации биомассы микроорганизмов

Изучение и поиск новых ассоциаций микроорганизмов для разрабатываемых технологий

Разработка и внедрение алгоритмов управления биотехнологическими процессами

Применение искусственного интеллекта для моделирования ассоциации бактерий с последующим использованием в добыче металлов
Образование
- 01
Создание
новых образовательных программ в соответствии с кадровыми потребностями ГОК
- 02
Развитие
образования в сфере биогеотехнологий, формирование в институте передовой научно-технологической базы
- 03
Проведение
научных исследований в проблемном поле науки с широким участием студентов, регулярных профессиональных обсуждений исследовательских проектов и их результатов в формате семинаров (круглых столов)
- 04
Взаимодействие
с российскими и зарубежными учебно-научными центрами
- 05
Поддержка
участия института в научных конференциях, семинарах, симпозиумах, круглых столах, проводимых в России и за рубежом
Команда проекта

Барышев Руслан Александрович
Основатель Центра, проректор по научной работе СФУ

Белый Александр Васильевич
Руководитель по технологиям и производству

Алгебраистова Наталья Константиновна
Руководитель по науке и образованию

Молокеев Максим Сергеевич
Руководитель по машинному обучению и искусственному интеллекту в биотехнологиях

Ананенко Екатерина Сергеевна
Ключевой исследователь

Прокопьев Иван Владимирович
Эксперт по биопереработке сырья

Плотников Иван Сергеевич
Эксперт по горнодобывающей промышленности

Яценко Алина Владимировна
Менеджер по медиа и стратегии